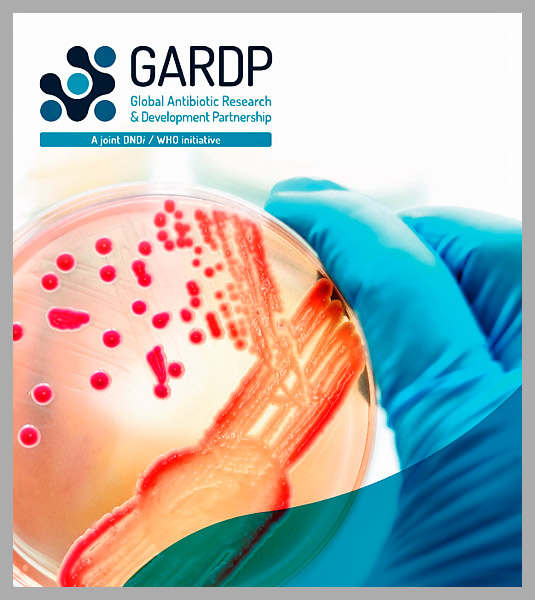

Nederland investeert 2 miljoen euro in nieuwe antibiotica
Nieuws -> GezondheidBron: Rijksoverheid
04-09-2017
Nederland investeert 2 miljoen euro in de ontwikkeling en productie van nieuwe antibiotica. Dat heeft minister Edith Schippers (Volksgezondheid) bekend gemaakt. In Berlijn is vandaag een internationaal evenement om geld op te halen tegen antibioticaresistentie. Ook andere landen waaronder Duitsland en Zwitserland zegden een bijdrage toe. Het geld is bedoeld voor het Global Antibiotic Research and Development Partnership (GARDP). Dit samenwerkingsverband is een initiatief van de Wereld Gezondheids Organisatie (WHO) en het Drugs for Neglected Diseases Initiative (DNDi). Het is opgericht met behulp van een bijdrage van Nederland, Duitsland, het Verenigd Koninkrijk en Zuid Afrika. Doel is om gezamenlijk nieuwe antibiotica te ontwikkelen en te produceren.

(Bron Rijksoverheid - 2015)
Edith Schippers minister van Volksgezondheid, Welzijn en Sport
Schippers: 'We weten, dat de huidige businessmodellen voor de ontwikkeling van nieuwe antibiotica niet werken. We hebben dringend behoefte aan goed werkende en betaalbare antibiotica die op een verantwoorde manier worden gebruikt. Dit is precies, waar GARDP zich voor inzet en waarom Nederland GARDP al vanaf het begin steunt. Ik hoop, dat andere landen snel aansluiten: geen woorden maar daden!’
Antibioticaresistentie. Antibioticaresistentie is een wereldwijde bedreiging voor de volksgezondheid. Kern van het probleem is, dat door onzorgvuldig gebruik steeds meer bacteriën ongevoelig worden voor de werking van antibiotica. Gevolg is, dat nu eenvoudig te genezen ziektes (zoals long- of blaasontsteking) weer levensbedreigend kunnen worden. Naar schatting van de Organisatie voor Economische Samenwerking en Ontwikkeling (OESO) vallen er wereldwijd jaarlijks ca 700.000 doden als gevolg van antibioticaresistentie. Er is daarom dringend behoefte aan nieuwe antibiotica die resistent geworden bacteriën tegen kunnen gaan. Om nieuwe resistentie te voorkomen, is het de bedoeling, dat deze middelen zo min mogelijk gebruikt worden. Daardoor is de ontwikkeling van nieuwe antibiotica commercieel niet aantrekkelijk.
(Bron GARDP - 2017)
De eerste pagina van het ondernemingsplan van Global Antibiotic Research and Development Partnership (GARDP)
Businessplan. GARDP heeft een businessplan (pdf 16 pagina’s) opgesteld om concreet een aantal nieuw antibiotica te ontwikkelen. Door slim onderhandelen wordt optimaal gebruik gemaakt van bestaande kennis en kunde van het bedrijfsleven. Vooraf worden afspraken gemaakt over toegang, prijzen en patenten. Het is een bewezen effectief model dat al jaren wordt ingezet voor ontwikkeling van geneesmiddelen tegen armoedegerelateerde ziekten. De moederorganisatie van GARPD, DNDi, heeft op deze manier al enkele nieuwe producten op de markt gebracht die wereldwijd worden toegepast. GARDP richt zich op nieuwe middelen die zowel relevant zijn voor Westerse landen als ontwikkelingslanden.
Schippers heeft de afgelopen jaren in haar internationale contacten (met landen als VS, Canada, Verenigd Koninkrijk, Zweden, China, Brazilië, Rusland, Indonesië en India, maar vooral ook met de WHO) hoge prioriteit gegeven om de mondiale bestrijding van antibioticaresistentie van de grond te krijgen. De aanpak van antibioticaresistentie was ook een prioriteit tijdens het Nederlandse voorzitterschap van de EU.



